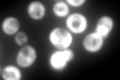
YLR249W
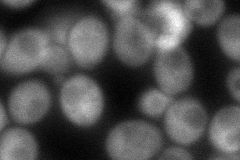
YLR249W

View description
Translational elongation factor 3, stimulates the binding of aminoacyl-tRNA (AA-tRNA) to ribosomes by releasing EF-1 alpha from the ribosomal complex; contains two ABC cassettes; binds and hydrolyses ATP
Localization:
Intensity:
Fold change:
Significance:
-
C’ GFP library in SD
cytosol2532.76 -
N' NOP1pr-GFP in SD

cytosol1550.87 -
N' TEF2pr-mCherry in SD

missing0 -
N' NATIVEpr-GFP in SD

below threshold20.3097 -
N' TEF2pr-VC and Cyto-VN in SD
cytosol93.6663 -
C’ GFP library in SD+DTT

cytosol1937.760.76No -
C’ GFP library in SD+H2O2

cytosol1973.620.77No -
C’ GFP library in Starvation Media

cytosol852.310.33Yes -
C’ GFP library on the background of Pup2-DaMP

N/A -
C’ GFP library on the background of CCT mutant

N/A0N/AYes
